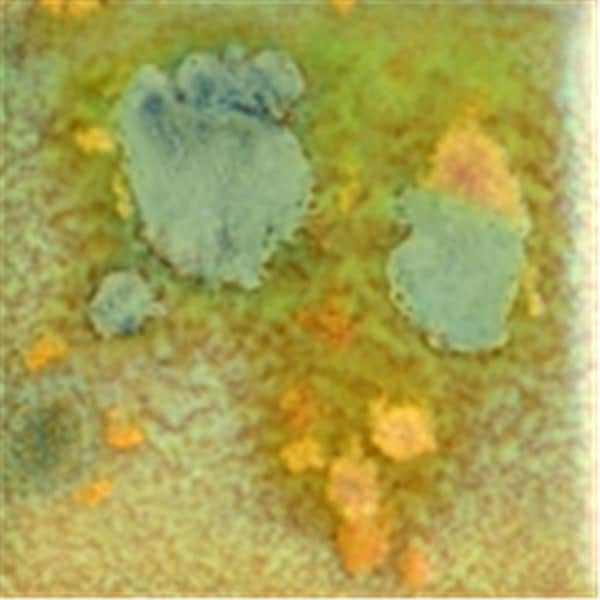

Elements Chunkies Non-Toxic Ceramic Glaze, 1 Pint, Gold Mine
Mfr # IN534231
Zoro # G115962702
product price:Â $44.79
/eaGet a 10% off coupon
Free 30-day returns
Return PolicyGet 30 days to pay with Net 30
Apply NowUnlock tax-exempt savings
Add Tax ExemptionSpecifications
Product Information
MFR #
IN534231
Zoro #
G115962702
UPC #
723902027813
Country of Origin
China
Description
Elements Chunkies Gold Mine Ceramic Glaze comes in a container of 1 pt. capacity and is ideal for achieving a high fire look at low fire temperatures. Non-Toxic glaze with crystals is easy to apply and spread out during firing to give a burst of color for a truly unusual appearance.
Restrictions
WARNING:
Cancer and Reproductive Harm
For more information go to
www.P65Warnings.ca.gov
Ratings & reviews
3 reasons you can count on us
Supplies for every job.
10 million items and the exact one you need.
When you need it fast, count on Zoro!
2 million products ship in 1 day.
Stretch your budget further.
Everyday low prices on the brands you love.